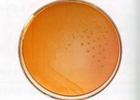
（圖）艱難梭狀芽孢桿菌小腸結腸炎

艱難梭狀芽孢桿菌
艱難梭狀芽孢桿菌艱難梭狀芽孢桿菌小腸結腸炎(clostridium difficile enterocolitis )是因使用抗生素導致腸道菌群失調,由難辨梭狀芽孢桿菌在腸道大量繁殖引起的腸炎。嚴重者大便排出片狀黏膜,曾稱假膜性腸炎,本病由於廣泛使用抗生素而日益增多,又稱抗生素相關性腸炎,是一種常見的醫院內感染性疾病。艱難梭菌腸炎多系醫院內感染,幾乎所有抗菌藥物均可誘發本病。人群中發病率極低。發病者絕大多數為老年人。
病因
本菌屬革蘭陽性專性厭氧菌能形成芽孢。在普通培養基上不易生長。接種於選擇性培養基,在厭氧環境下生長迅速。採用血清凝集試驗可將該菌分為Ⅰ、Ⅱ、Ⅲ和Ⅳ4個血清型。其中以Ⅰ型菌株毒力最強,從假膜性腸炎患者分離的菌株均為Ⅰ型:Ⅱ、Ⅳ型產毒素少,Ⅲ型不產生毒素。艱難梭狀芽孢桿菌小腸結腸炎是因使用抗生素導致腸道菌群失調,由難辨梭狀芽孢桿菌在腸道大量繁殖引起的腸炎。嚴重者大便排出片狀黏膜,曾稱假膜性腸炎,本病由於廣泛使用抗生素而日益增多,又稱抗生素相關性腸炎,是一種常見的醫院內感染性疾病。
發病機制

青黴素
難辨梭狀芽孢桿菌產生的毒素有A毒素、B毒素、蠕動改變因子和不穩定因子A毒素引起腺體分泌黏膜損傷及炎症。B毒素沒有腸毒活性,但可在A毒素作用的基礎上加重黏膜病變。現多認為毒素A在難辨梭狀芽孢桿菌致病機制中可能有重要意義。蠕動因子能刺激肌肉收縮加劇腹痛和腹瀉不穩定因子在致病中的作用尚不了解。可誘發本病的抗生素有多種:青黴素、半合成青黴素、頭孢菌素、氯黴素、林可黴素、四環素、氨基糖甙類等,其中以半合成青黴素、頭孢菌素及林可黴素為多。
病理改變多在乙狀結腸和直腸。約1%~10%的病變局限在較近端結腸個別報告以小腸病變為主。腸壁散在黃白色斑塊樣隆起,約1~10mm,圓形或橢圓形間以正常或紅斑黏膜可融合成片狀灰綠色或棕色的偽膜,偽膜脫落處可見潰瘍。顯微鏡下可見腸黏膜固有層、黏膜下層有炎性細胞浸潤,偽膜由中性粒細胞、炎症細胞、纖維素及上皮細胞碎片組成。
臨床表現
 艱難梭狀芽孢桿菌
艱難梭狀芽孢桿菌約1/2~2/3的患者發生於抗菌藥物治療後4天內。按病情分輕、中、重型。
1、輕型,每天稀便3~4次黃綠色黏液便,大便可有膿細胞,隱血試驗陽性可伴發熱和腹痛腸鏡檢查見腸黏膜正常或輕度水腫有典型米粒狀隆起擦之即脫落,露出潰瘍。停用抗菌藥物數天症狀即緩解。
2、中型(典型),腹瀉每天10餘次,大便呈蛋花樣,有假膜和血便,伴發熱和腹痛。外周血中性粒細胞增加,血清α1-球蛋白升高,血清鉀、鈉和白蛋白降低。
3、重型,腹瀉每天20餘次,大便量多,奇臭常有血便,假膜呈大片或管狀。發熱和毒血症表現較重,短期內出現低蛋白血症。常因脫水電解質紊亂、休克、DIC、腸出血或腸穿孔而陷入危重狀態,預後較差。
併發症
重症患者可合併電解質紊亂、休克、DIC、低蛋白血症、腸出血、腸穿孔以及膿腫、血管栓塞、中毒性巨結腸等偶有多發性關節炎。
診斷
服用抗菌藥物後出現上述典型臨床表現者即應考慮本病,特別是對老年人更應提高警惕。有假膜排出的典型病例停用抗菌藥物或加服萬古黴素治療後病情好轉者,有助於本病的診斷對輕型病例,明確臨床診斷的最好方法是結腸鏡檢查,應仔細觀察各部位黏膜,因為隆起的黃色小斑塊易碎並可被充血、黏液、糞渣所掩蓋。病原體培養及毒素檢測對診斷有較重要的參考價值。
鑑別
本病需與各種感染性腹瀉、潰瘍性結腸炎、克羅恩病和結腸癌等相鑑別,感染性腹瀉如真菌性腸炎、葡萄球菌腸道感染和急性出血性腸炎等。
檢查
 血象-白細胞
血象-白細胞實驗室檢查:
1、血象:多數患者白細胞計數升高,可高達60×109/L中性粒細胞增加。
2、大便塗片檢查可見白細胞革蘭染色可見大量陽性桿菌,採用CCFA培養基則85%患者的糞便中可分離出難辨梭狀芽孢桿菌,並可用生化試驗或氣-液相色譜加以鑑定。
3、組織培養:可檢出糞便中低至10pg的細胞B毒素。此法需細胞培養設備。
4、採用的ELISA方法能檢測在100~1000pg水平的A毒素或B毒素快速、正確、敏感和經濟。
相關檢查:
> 葉酸
> 白細胞計數
治療
初步診斷後應立即停用抗菌藥物,如病情需要則應該用很少誘發本病的抗菌藥物。輕症病例停用抗菌藥物後可自愈病情較重,大便中有假膜者則宜用萬古黴素,500~2000mg/d,分4次口服。甲硝唑適用於缺乏萬古黴素或萬古黴素治療後的復發病例,用法:600~1200mg/d,分2~3次口服,療程均為7~10天。
預後及預防
預防:
輕症患者停用抗生素後數天症狀緩解,重型有併發症者預後較差。
預防:
注意飲食衛生避免食物和飲水被污染冷藏食品應加熱煮沸處理後才能食用。避免與病人和有病的動物接觸。

